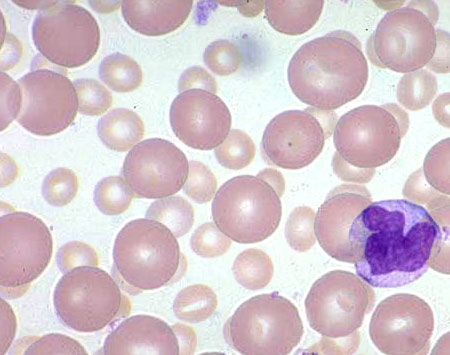
Leczenie podtrzymujące rytuksymabem po immunochemioterapii indukcyjnej u chorych na chłoniaka z komórek płaszcza: wyniki długookresowej obserwacji badania z Wisconsin Oncology Network

Leczenie chorych na chłoniaka z komórek płaszcza (MCL, Mantle Cell Lymphoma) pozostaje wyzwaniem współczesnej hematoonkologii. Mimo, że od wyodrębnienia tej rzadkiej jednostki chorobowej upłynęło już ponad 20 lat, to do chwili obecnej nie udało się jednoznacznie ustalić standardu postępowania terapeutycznego, a choroba uznawana jest za nieuleczalną.
Materiał przeznaczony wyłącznie dla pracowników służby zdrowia
Ten materiał jest dostępny dla zarejestrowanych użytkowników.
Zaloguj się
Szanowni użytkownicy,
część materiałów udostępnianych na naszym portalu jest przeznaczona
wyłącznie dla lekarzy.
Wynika to z regulacji prawnych, do których musimy się stosować.
Jeśli nie jesteś lekarzem, zachęcamy do korzystania z przygotowanych przez nas materiałów dostępnych w zakładce dla pacjentów.











